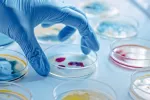

Síntomas de leucemia

Por: Esther Martín
Estudiante de medicina de la Universidad de Alcalá de Henares
Actualizado: 21 de septiembre de 2022
La clínica de la leucemia depende, por un lado, de la insuficiencia medular provocada por el crecimiento de las células cancerosas, que impide el crecimiento del resto de células, y por otro lado, de la infiltración de estas células anómalas en órganos y tejidos. Este tipo de cáncer de la sangre compromete a los glóbulos blancos, encargados de combatir las infecciones, impidiendo que funcionen correctamente.
El comienzo es casi siempre agudo, de forma brusca (excepto en los tipos crónicos), y el tiempo que transcurre entre la aparición de los síntomas de leucemia y el momento del diagnóstico generalmente no sobrepasa los tres meses.
Lo normal es que los pacientes presenten síntomas en el momento del diagnóstico, pero a veces permanecen asintomáticos (sin síntomas) y la leucemia se diagnostica al realizar una analítica de sangre. Aunque depende del tipo de leucemia que padezca el paciente, con frecuencia refieren astenia (cansancio persistente), anorexia (falta de apetito) y pérdida de peso. La mitad de los pacientes presentan fiebre o escalofríos y sudoración, sobre todo nocturna. En el 50% de los enfermos se aprecia diátesis hemorrágica cutánea o mucosa (predisposición a presentar hemorragias y cardenales en la piel o las mucosas).
Puede haber dolores articulares y óseos, sobre todo en los niños. Lo más frecuente es que las células leucémicas invadan el hígado, el bazo y los ganglios linfáticos, produciendo hepatoesplenomegalia (aumento del tamaño de hígado y bazo) y adenopatías. En ocasiones puede afectarse el sistema nervioso, con parálisis de nervios o aumento de la presión intracraneal (dentro del cráneo). La afectación de otros órganos es rara, aunque en las recaídas pueden afectarse las mamas, los testículos y la piel o las mucosas.
Creado: 4 de febrero de 2011